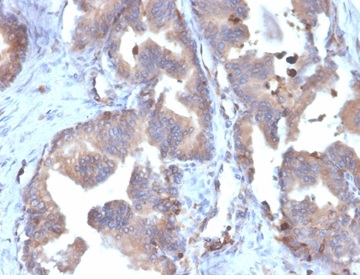

Formalin-fixed, paraffin-embedded human liver metastasized to colon stained with FABP5 Recombinant Rabbit Monoclonal Antibody (FABP5/6353R).
Formalin-fixed, paraffin-embedded human prostate carcinoma stained with FABP5 Recombinant Rabbit Monoclonal Antibody (FABP5/6353R).

SDS-PAGE Analysis Purified FABP5 Rabbit Recombinant Monoclonal Antibody (FABP5/6353R). Confirmation of Purity and Integrity of Antibody.
This gene encodes the fatty acid binding protein found in epidermal cells, and was first identified as being upregulated in psoriasis tissue. Fatty acid binding proteins are a family of small, highly conserved, cytoplasmic proteins that bind long-chain fatty acids and other hydrophobic ligands. FABPs may play roles in fatty acid uptake, transport, and metabolism. Polymorphisms in this gene are associated with type 2 diabetes. The human genome contains many pseudogenes similar to this locus. FABP5 is also associated with poor survival in triple-negative breast cancer. Additionally, FABP5 gene is upregulated in colorectal cancer cells compared to normal colon cells in a manner that correlates with disease stage and that FABP5 significantly promotes colorectal cancer cell growth and metastatic potential.
There are no reviews yet.